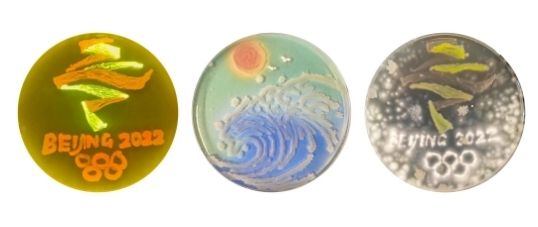

什么?
这些实验课还教
做美食、香皂、修复文物
……
和团团一起来看看吧~
上过这门课的同学都成了美食家

“腊肠居然可以这么好吃”
“上完这门课,我只想说,真香啊”
浙江大学这门《动物产品加工实验》课
同学们纷纷点赞称好
据该实验课的任课老师介绍
课程主要涉及
乳品科学、肉品科学和蛋品科学三方面
以理论和实验相结合的方式开展

老师会在实验课前
先介绍实验流程和要点
给出制作配方
教大家如何控制配料和火候
同时示范各种机器的用法
按照老师给出的配方
即使是从未学过烹饪的“小白”
做出来的食物也是既好看又好吃
同学们不禁感叹
“原来食品加工真的是一门科学!”

老师还给出了一套食品评价标准
“比如东坡肉
我们会用筷子插
感受肉的嫩度
还要看红烧肉里面的味道
有没有完全渗透进去”
“自己做的红烧鱼就是好吃呢!”
四川农业大学食品科学与工程专业
老师布置了一项特别的作业
让学生在课堂上自制红烧鲤鱼罐头
同学们纷纷表示
“能吃到自己做的罐头,太幸福了!”
此次实验原料采用的是
四川省的优势淡水鱼种鲤鱼
由于鲤鱼属于大众经济淡水鱼类
正值产量丰厚的季节
可以很好地利用

老师选择这个鱼种
旨在引导学生们因地制宜
充分利用好身边的资源
实验分为以下几个阶段
首先,处理原料
其次,将鱼进行宰杀、清洗、切块等操作
然后进行油炸
将鱼头与香辛料调味后
熬煮半个小时左右
接着趁热进行密封装罐
最后,高温灭菌

在整个实验过程中
同学们的积极性很强
尤其是在炸鱼和调制调味料时
实验室弥漫着香气
在场学生直流口水
参与这堂实验课的同学表示
“这次实验让我增进了对课程的理解
知道了实验不是冷冰冰的参数
非常有趣”
培养基里的小熊

这是天津大学化工学院
一名同学的新年朋友圈
由萌萌的小老虎图案
和2022字样组成
这个图案是她在大肠杆菌里
导入红色荧光蛋白和绿色荧光蛋白之后
在培养基中孵化完成的
而“微生物绘画”正是她本学期
《微生物学实验课》期末考试的内容之一

通过这门课
同学们要掌握
微生物分离、培养等无菌操作技术
同时还要认知
细菌、霉菌、放线菌、酵母菌等
十余种微生物的典型形态和生长特性
学生自制透明皂送恋人
自制透明皂是四川农业大学
一堂实验课的课程内容
许多学生将自己亲手制作的透明皂
送给恋人、亲友
收到礼物的同学表示
“真是看得见的工艺
感受得到的心意”
实验课的成品
都是与生活有关的产品
所用原材料均经过老师挑选审核
安全可靠
可以直接拿来使用
为了增加实验的趣味性
老师准备了各式各样的软胶模具

同学们表示
实验中最难的部分
是把搅拌好的溶液倒入模具
让它成型的那一刻
既想让色素分布地比较均匀
又要避免样液过快凝固
这就需要操作足够迅速
否则就会出现渣滓和色素斑点
但这也是最难忘的瞬间
当它凝固成型的那一刻
太让人惊喜了
“我揭开了文物的神秘面纱!”

在纪录片里
修文物是一门高深玄妙的“老手艺”
而在北京大学
文物保护与修复褪去了神秘的面纱
成为一门理论与实践相结合的科学课程
在《无机质文物保护与实验》的课堂上
一名同学正在修复一尊造型独特的陶器

她介绍说
这是从北京通州区出土的汉代陶温鼎
功能类似于现代的火锅
这件器物分为上下两层
是墓葬中的随葬品
它出土时早已碎成了若干残片
而将一堆残缺的陶片
还原成一件完整的器物
修复过程并不轻松

在老师和师兄的指导下
从清理到黏结
都是由她亲手完成
黏结完毕的陶“火锅”依然有缺损的地方
“我们会用‘独家秘方’把它补全”
故宫里的文物修复师
师徒相承、继承和发展传统手工艺
是给文物治病的“中医”
而北京大学校园里的这群人
则更像是“西医”
他们以化学知识为基础
借助X射线、电子显微镜等现代技术手段
为文物“诊断”和“治疗”

不断学习与实践
课堂内外
都活跃着这群年轻的“文物医生”们的身影
除了上面这些
你还知道哪些有趣的实验课
快来评论区和团团分享一下吧~



